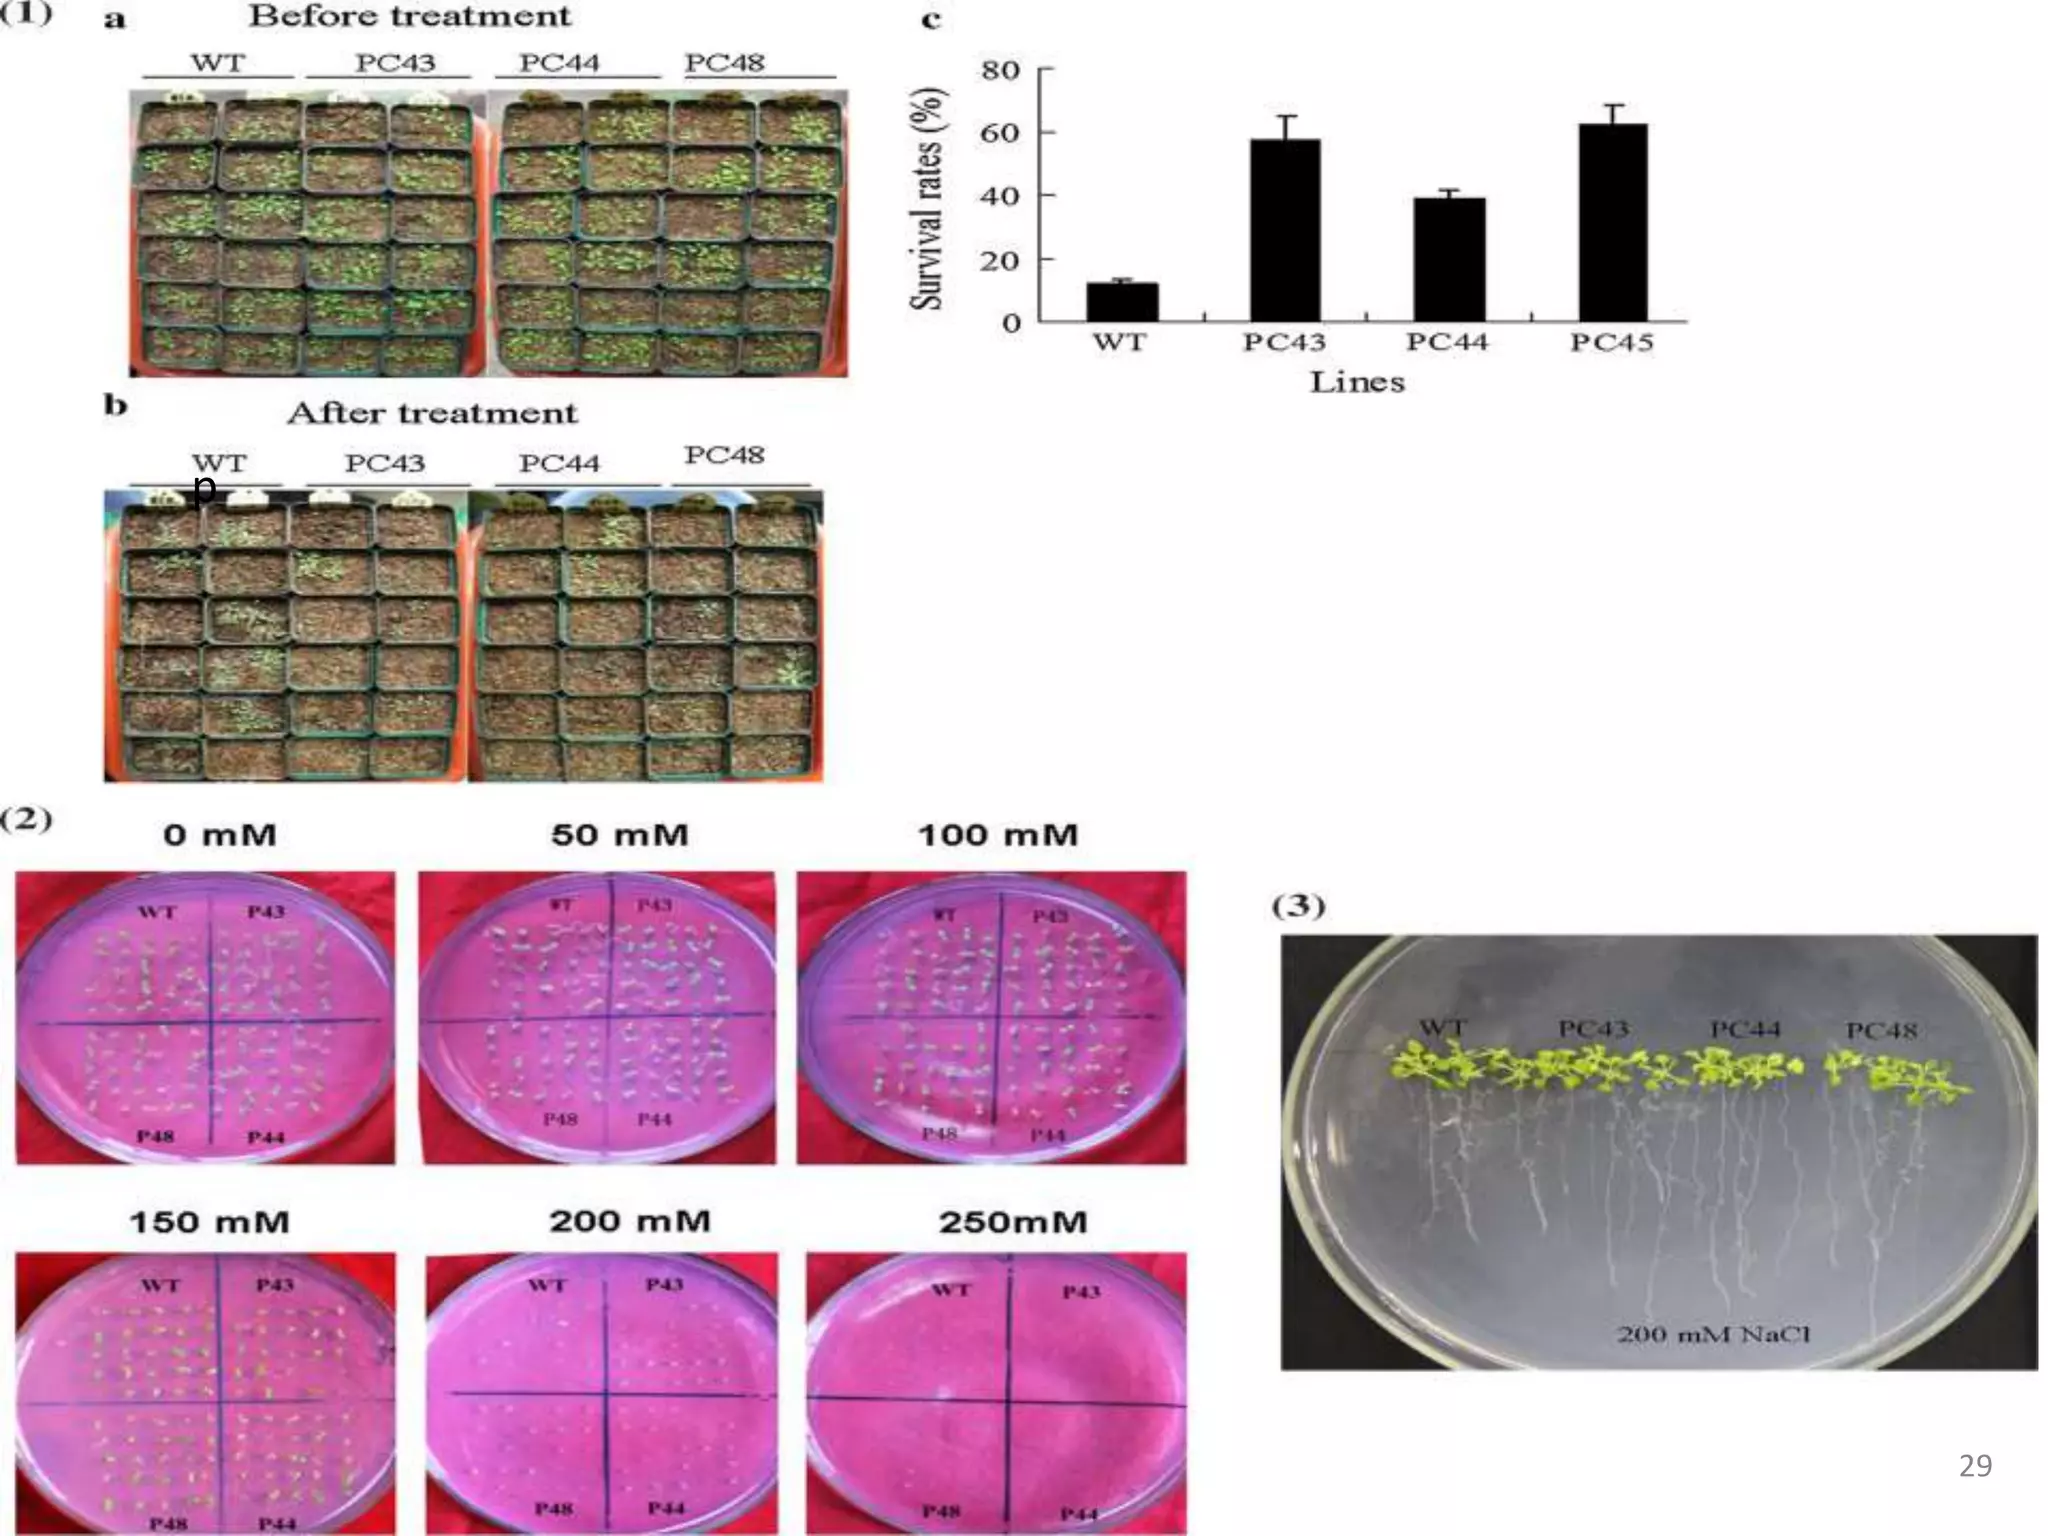
p
29

1. DREB genes play an important role in improving crop tolerance to stresses like drought, salt, and cold. DREB transcription factors regulate stress-responsive genes allowing plants to adapt.
2. Case studies showed overexpression of DREB genes enhanced stress tolerance in crops like rice and sugarcane. Co-transformation with DREB and other stress genes improved tolerance more than single DREB genes.
3. DREB genes respond differently to various stresses. DREB1 genes respond mainly to cold while DREB2 genes respond to dehydration and heat. Proper expression analysis of DREB genes is important for abiotic stress tolerance in transgenic crops.